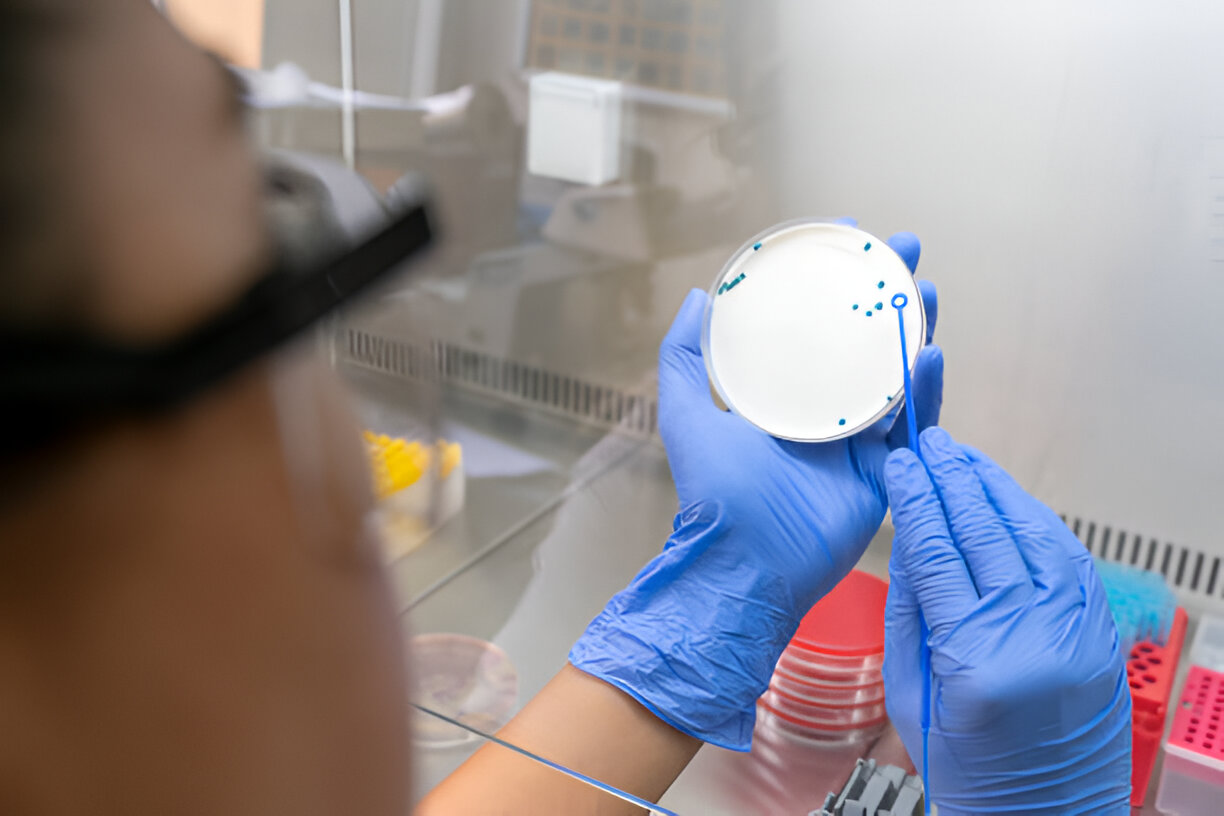

PRIMARY CARE SERVICES
AHWATUKEE FOOTHILLS
Ask Us Anything
Primary Care Services at Shafa Medical Clinic
At Shafa Medical Clinic, we offer comprehensive Primary Care Services designed to support your overall health and wellness. Having a dedicated Primary Care Physician is essential for managing your day-to-day health, preventing illness, and addressing any concerns that may arise. Our team of skilled Primary Care Staff and Internal Medicine Doctor provide personalized care to ensure you receive the attention you need, whether for routine check-ups or treatment of acute and chronic conditions. Let us be your trusted partner in health, guiding you toward a healthier future.

About Us

Follow Us
Our Primary Care Services
At Shafa Medical Clinic, we are dedicated to delivering comprehensive Primary Care Services to support your health and well-being. Our experienced team, including skilled Primary Care Physician and Internal Medicine Specialist, is committed to addressing a wide range of medical conditions and providing personalized treatments tailored to your unique needs.
Here is a list of the primary care services we offer:
Allergic Reactions and Allergies
Primary Care Physician for Allergies: Our doctor are experts in diagnosing and treating allergies and allergic reactions. From seasonal allergies to food and environmental triggers, we provide effective management strategies to reduce symptoms and improve quality of life.
Abscess Incision and Drainage
If you are suffering from an abscess, our team can perform a safe and effective abscess incision and drainage procedure to remove infection and promote healing.
Asthma
Family Medicine for Asthma: Our physician provide comprehensive asthma care, including treatment plans, medication management, and symptom monitoring to help you breathe easier and lead a normal life.
Athlete’s Foot/Fungus Infection
Primary Care Doctor for Fungus Infections: Athlete’s foot and fungal infections are common conditions treated at our practice. We offer antifungal treatments to alleviate discomfort and prevent recurrence.
Bronchitis
Primary Care Physician for Bronchitis: Whether acute or chronic, we specialize in treating bronchitis with a focus on symptom relief and preventing further complications.
Congestion and Cough
Primary Care for Respiratory Issues: Our doctor treat common respiratory conditions like cough and congestion, helping you recover quickly and effectively from cold and flu symptoms.
Eczema
Eczema: We offer expert treatment for skin rashes, providing soothing solutions to alleviate discomfort and prevent future outbreaks.
Ear Infections and Earaches
Ear Infection Treatment: We treat both ear infections and earaches, offering prescription medications and advice on prevention for all ages.

Eye Infections
Primary Care for Eye Infections: Whether viral or bacterial, we provide effective treatments for eye infections, ensuring your vision and eye health are protected.
Fever and Flu Symptoms
Family Medicine for Flu Symptoms: From fever to chills and muscle aches, our physician help you manage flu symptoms and recover quickly.
Gastrointestinal Disorders
Primary Care for Digestive Health: We offer treatment for a wide range of gastrointestinal disorders, from nausea and stomach aches to acid reflux and gastroenteritis.
Insect Bites
Primary Care for Insect Bites: Insect bites can cause discomfort and infection. We provide effective treatments to relieve itching and swelling and prevent further complications.
Itchy Skin and Rashes
Skin Allergy and Rash Treatment: Our doctor offer treatment for itchy skin, rashes, and skin allergies, helping you find relief from irritation and inflammation.
Kidney Stones
Internal Medicine for Kidney Stones: If you’re dealing with the pain of kidney stones, our physician offer a range of treatment options to relieve discomfort and prevent future stones from forming.
Migraine
Primary Care for Migraines: We specialize in treating migraines, providing medication, lifestyle recommendations, and preventive care to reduce frequency and severity.

Nausea and Vomiting
Treatment for Nausea and Stomach Pains: Our doctor offer diagnosis and treatment for nausea and vomiting, helping you regain comfort and avoid complications.
Pneumonia
Primary Care for Pneumonia: Our Primary Care Physician specialize in diagnosing and treating pneumonia, offering medication and supportive care to help you recover fully.
Runny Nose and Sinus Infections
Treatment for Sinus Infections: If you’re dealing with a runny nose or a sinus infection, our doctor will provide treatments to relieve congestion and improve breathing.
Skin Infections and Wound Infections
Wound Infection Care: From minor wound infections to more serious skin infections, our team offers both treatment and prevention strategies to promote healing.
Sore Throat/Strep Throat
Primary Care for Sore Throat: Whether it’s a sore throat or strep throat, we provide diagnostic testing and treatment to help you recover quickly.
STD Testing and Treatment
Sexual Health Services: We offer STD testing and treatment in a confidential and compassionate setting, providing care for your sexual health and well-being.
Urinary Tract Infections (UTIs)
Primary Care for UTIs: Urinary tract infections are common but treatable conditions. Our doctor offer prompt diagnosis and antibiotic treatments to alleviate symptoms and prevent recurrence.
Yeast Infections
Treatment for Yeast Infections: If you’re suffering from a yeast infection, our physician offer effective antifungal treatments to restore balance and comfort.

We specialize in treating a wide range of conditions to ensure that you and your family stay healthy and thriving. Whether you need treatment for a common illness or ongoing care for chronic conditions, our Primary Care Physician and Internal Medicine Specialist are here to provide compassionate, high-quality care. Contact us today to schedule an appointment and begin your journey to better health!
Podcasts About Diseases

Hearing loss and risk of dementia podcast
Hormone replacement therapy podcast women
Insulin Resistance and Prediabetes Podcast
Is Testosterone therapy right for you podcast
Vision loss and cognitive decline Podcast
What exactly is a lipid panel podcast intro
What is an autoimmune disease podcast
Diabetes insulin and treatments podcast
Common Health Issues We Treat
At Shafa Medical Clinic, our Primary Care Doctor in Ahwatukee Foothills are dedicated to addressing a wide range of health issues, ensuring that you receive the care and support you need for both acute and chronic conditions. Whether you're dealing with a sudden illness or managing a long-term health concern, our team is here to provide personalized and comprehensive care.

Skin Infections
Skin infections can vary from mild irritations to more serious conditions. Our Primary Care Physician are experienced in diagnosing and treating a range of skin issues, including bacterial and fungal infections. Whether it’s an infection caused by cuts, insect bites, or conditions like athlete’s foot, our physician offer effective treatment options to help you heal and prevent recurrence.

Kidney Stones
If you’re experiencing intense pain or discomfort, kidney stones could be the cause. Our Physician for Chronic Conditions in Phoenix are skilled in diagnosing kidney stones and providing solutions to manage symptoms, reduce pain, and prevent future occurrences. We work with you to create a treatment plan that suits your individual needs.

Nausea and Stomach Issues
Nausea can stem from various causes, including infections, gastrointestinal disorders, or other underlying conditions. Our Primary Care Doctor offer expert care for nausea, vomiting, and stomach discomfort. We provide accurate diagnoses and treatment plans to help alleviate symptoms and improve your digestive health.

Skin Allergies
Allergic reactions affecting the skin, such as rashes, hives, or eczema, are common issues we treat. Our Primary Care Doctor in Ahwatukee Foothills are equipped to identify the triggers of your skin allergies and provide relief through treatments, medications, and lifestyle recommendations. We take a holistic approach to ensure your comfort and well-being.

Respiratory Infections
Coughs, colds, bronchitis, and other respiratory infections are common issues we treat. Our physician focus on relieving symptoms, managing infections, and preventing complications, ensuring a quick recovery and improved respiratory health.

Urinary Tract Infections
Urinary tract infections are common but uncomfortable. If you’re experiencing symptoms such as painful urination or frequent urges to urinate, our physician can quickly diagnose and treat UTIs. We work to eliminate the infection and help prevent future occurrences with effective treatments and prevention tips.
Our Primary Care Doctor in Ahwatukee Foothills are committed to your health and well-being. Whether you’re seeking relief from a skin infection, managing kidney stones, or looking for ongoing care for chronic conditions, we are here to provide the expertise and support you need. Contact us today to schedule an appointment with one of our experienced physician!
Why Choose Shafa Medical Clinic for Your Primary Care?
At Shafa Medical Clinic, we understand that choosing the right healthcare provider is one of the most important decisions you can make for your well-being. As a leading Internal Medicine Clinic in Ahwatukee Foothills. We are dedicated to providing exceptional care for both acute and chronic conditions. Our team of experienced primary care doctor and staff in Ahwatukee Foothills are here to support your health every step of the way.
Expertise in Treating Both Acute and Chronic Conditions
Our Internist in Ahwatukee Foothills have extensive experience in diagnosing, treating, and managing a wide variety of health conditions, from common illnesses like colds and flu to more complex chronic conditions such as diabetes, hypertension, and heart disease. Whether you’re dealing with a sudden health issue or require long-term management of a chronic condition, our team is here to provide expert care tailored to your individual needs.
We take a compassionate, patient-centered approach to medicine, ensuring that you receive the highest quality care in a comfortable and welcoming environment. Our physician are dedicated to keeping you healthy and helping you achieve your best quality of life.

Trusted by the Ahwatukee Foothills Community
We are proud to be recognized as one of the Best Internists in Ahwatukee Foothills. Our commitment to excellence has earned us the trust of our patients, who appreciate our holistic approach to primary care. But don’t just take our word for it—here’s what some of our patients have to say:

Compassionate Care, Close to Home
Our Primary Care Physician in Ahwatukee Foothills are more than just healthcare providers—they are partners in your health journey. We believe in building long-lasting relationships with our patients and working together to improve and maintain your health. Whether you need preventive care, treatment for an acute illness, or help managing a chronic condition, we are here for you.
If you’re looking for an Internist in Ahwatukee Foothills, who truly cares about your well-being, Shafa Medical Clinic is the right choice for you. Contact us today to schedule an appointment and experience the difference that compassionate, expert care can make.
Treatment for Specific Conditions
At Shafa Medical Clinic, we specialize in the treatment of a wide range of specific conditions, providing comprehensive care to ensure you receive the best possible treatment. Our Primary Care Physician are dedicated to diagnosing and managing conditions such as pneumonia, STD testing and treatment, gastrointestinal disorders, stomach aches, and yeast infections. Whether you're experiencing an acute illness or managing a chronic condition, we’re here to help you regain your health and well-being.

Pneumonia Treatment
Pneumonia is a serious lung infection that requires prompt treatment. Our Primary Care Physician are skilled in diagnosing and managing pneumonia, offering a combination of antibiotics, rest, and supportive care. We ensure you have the proper treatment plan to recover fully and reduce the risk of complications. If you’re searching for an experienced Physician for Chronic Conditions or a Primary Care Physician Near Me, we provide personalized care for both acute and recurring cases of pneumonia.

STD Testing and Treatment
Sexually transmitted diseases (STDs) are a common concern, but with early detection and proper treatment, they can be managed effectively. Our clinic offers confidential STD testing and treatment services, providing peace of mind and ensuring your health is protected. Our Primary Care Physician offer a wide range of testing options and treatment plans tailored to your needs. If you need an Internal Medicine Specialist for STD concerns, we are here to provide expert care in a safe, professional environment.

Gastrointestinal Disorders
Chronic gastrointestinal issues like irritable bowel syndrome (IBS), acid reflux, and ulcers can significantly impact your quality of life. At Shafa Medical Clinic, we offer comprehensive care for gastrointestinal disorders, helping you manage symptoms through dietary advice, medication, and lifestyle changes. Our Primary Care Physician Near Me are well-versed in managing complex GI conditions, working with you to create a treatment plan that addresses your specific needs and improves your digestive health.

Stomach Aches and Pain Management
Stomach aches and abdominal pain can be caused by a variety of factors, from minor digestive issues to more serious conditions. Our Internal Medicine Physician are experienced in diagnosing the underlying causes of stomach pain and providing effective treatment options. Whether you’re dealing with a temporary discomfort or a chronic issue, we can help manage your pain and get you back to feeling your best.

High Blood Pressure Management
High blood pressure, or hypertension, is a silent condition that can lead to severe complications if left untreated. Our team provides regular monitoring, lifestyle guidance, and medication management to keep your blood pressure under control and reduce your risk of heart disease and stroke.
Yeast Infections
Yeast infections are a common issue, particularly among women, and can be both uncomfortable and disruptive. Our team at Shafa Medical Clinic is experienced in diagnosing and treating yeast infections, providing appropriate antifungal treatments and advice on how to prevent future occurrences. If you’re struggling with recurrent infections or need advice on how to manage symptoms, our Primary Care Physician are here to help.
At Shafa Medical Clinic, we’re committed to offering expert treatment for chronic conditions and specific health issues, ensuring that you get the care you deserve. Whether you’re in need of immediate assistance or long-term care, our team of primary care doctor and staff is here to guide you toward a healthier future. Contact us today to schedule your appointment and take the first step toward better health.
Meet Our Team
Meet our compassionate and experienced team at Shafa Medical Clinic. Dedicated to providing exceptional care for your health and well-being.
Dr. Amanda Modesta Keyhani
Board Certified in Internal Medicine
Board-certified in Internal Medicine, delivering expert, trusted, and compassionate healthcare.
Camilla
Medical Assistant
Compassionate and skilled, Camilla supports patient care with precision and dedication.
Yvonne
Medical Assistant
Committed to excellence, Yvonne ensures patients receive seamless and attentive care.
Lani
Front Office Assistant
Lani greets every patient with a smile, ensuring a welcoming and organized experience.
FAQs About Primary Care Services
What are Primary Care Services?
Primary care services are the first line of healthcare that focuses on overall health and wellness. Our Primary Care Physicians provide comprehensive care, from preventative health screenings to managing chronic conditions. Whether you’re dealing with a common cold, allergies, or a chronic disease, our Internal Medicine Doctors are here to provide continuous and personalized care for you and your family.
Do you treat allergies?
Yes, our Primary Care Physicians are experienced in diagnosing and treating all types of allergies, including seasonal, food, and skin allergies. We offer personalized care and treatment plans, such as allergy testing and immunotherapy, to help you manage and alleviate symptoms effectively.
What should I expect during my visit to a Primary Care Doctor?
When you visit our practice, your Primary Care Physician will begin by reviewing your medical history and conducting a physical examination. Depending on your symptoms, further tests or screenings may be recommended. Our goal is to ensure you receive a thorough evaluation and personalized care plan tailored to your health needs.
Do you accept insurance?
Yes, we accept a wide range of insurance plans. We recommend contacting our office or checking with your insurance provider to confirm coverage. Our team will also assist in verifying your insurance details before your visit. Our focus is to make accessing Primary Care Services as easy as possible.
How can I make an appointment with an Internal Medicine Doctor?
Making an appointment with one of our Internal Medicine Doctors is easy. You can call our office or schedule an appointment online through our website. If you’re experiencing urgent health concerns, we also offer same-day appointments when available.
What conditions do Primary Care Physician treat?
Our Primary Care Doctors treat a wide variety of conditions, including but not limited to asthma, bronchitis, skin infections, sinus infections, flu symptoms, migraine, nausea, UTIs, and more. We also specialize in managing chronic conditions like diabetes, high blood pressure, and heart disease. No matter your needs, we’re here to provide expert care.
Will I be referred to a specialist?
If needed, your Primary Care Physician may refer you to a specialist. However, our Internal Medicine Physicians are highly skilled in managing many conditions themselves. We strive to offer comprehensive care so that you don’t always need to see a specialist unless necessary.
Can I see a doctor if I don’t have a regular Primary Care Physician?
Yes, we welcome new patients without a regular Primary Care Doctor. Our team of experienced Internists is here to provide the care and support you need. Whether it’s for a routine checkup or specific health concerns, we’re here to help.
How often should I visit my Primary Care Physician?
We recommend annual checkups for most adults to monitor your health and prevent potential issues. However, if you have a chronic condition or specific health concerns, more frequent visits may be necessary. Your Primary Care Physician will guide you on the best schedule for your health needs.
What is the difference between a Primary Care Physician and an Internist?
An Internist is a type of Primary Care Doctor who specializes in adult medicine. Internal Medicine Doctors have in-depth knowledge of the diagnosis and treatment of chronic conditions, illnesses, and complex health issues. They often manage more intricate health problems than general family physicians and focus on adult patients.
If you have more questions or need further information about our Primary Care Services, feel free to contact us. We’re here to help you achieve and maintain optimal health!





